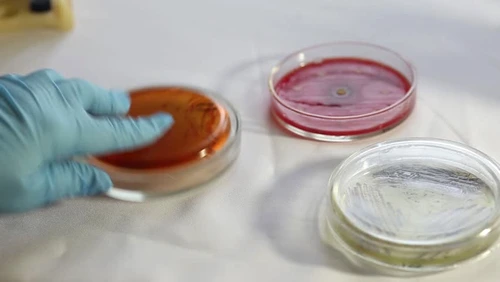
1 71324 original jpg jpeg

Ce este listerioza şi cum o eviţi
Afecţiune rară, produsă de bacteria Listeria monocytogenes, listerioza poate pune viaţa în pericol dacă nu este depistată şi tratată din timp. Infecţia este mai periculoasă la persoanele în vârstă, la cele care au un sistem imunitar slăbit şi la gravide.
Bacteria Listeria monocytogenes poate invada corpul prin tractul gastro-intestinal. Odată ajunsă în organism,ea poate călători prin fluxul sangvin,producând toxine care distrug celulele. Ea se dezvoltă cel mai bine în sistemul nervos central la persoanele cu sistem imunitar slăbit,provocând meningită şi/sau encefalită (infecţie a creierului).
Bacteria rezistă în medii reci
Bacteriile sunt peste tot:se găsesc în sol,apă şi în multe produse alimentare,inclusiv în cele din carne,lapteşi brânzeturi. Dar,spre deosebire de alţi germeni,care tind să moară sau să se înmulţească foarte lent în condiţii de refrigerare,Listeria monocytogenes rezistă în medii reci. De fapt,ea se poate găsi în fructele de mare afumate,chiar şi după refrigerare.
O altă caracteristică ameninţătoare a acestei bacterii este că poate dura până la 70 de zile pentru a se face cunoscută după simptome,cum sunt febră,slăbiciune,vărsături,confuzie şi gât rigid,iar aceste semne pot dura săptămâni. Vestea bună este că,în urma unui tratament cu antibiotice,infecţia poate fi vindecată.
Câteva măsuri de prevenţie pentru a evita infectarea cu această bacterie
Centrul pentru Prevenirea şi Controlul Bolilor (SUA) recomandă spălarea foarte bine a produselor alimentare de bază. Asta înseamnă că trebuie să le speli cu multă apă înainte de preparare sau consum,chiar şi dacă acestea au coajă. De exemplu,pepenii şi castraveţii trebuie spălaţi cu apă din abundenţă şi uscaţi apoi cu o cârpă curată sau cu un prosop de hârtie.
Carnea nefiartă trebuie ţinută separat de toate celelalte produse alimentare,inclusiv de cele gătite şi preparate.
Bacteria Listeria monocytogenes poate fi distrusă în timpul preparării alimentelor şi a pasteurizării laptelui. De aceea,pregăteşte alimentele cu atenţie!






























